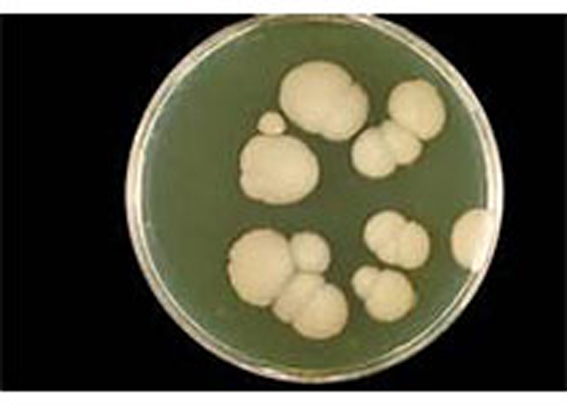
新改image001.jpg

行业资讯
国产首个细菌检验质谱仪进入临床应用
据了解,这款可对细菌蛋白质组、基因组进行全方位研究的先进质谱仪由毅新博创公司研发,于2012年通过了欧盟CEIVD认证,2014年通过中国食品药品监督管理总局认证。它能够快速检测识别革兰氏阴性菌,而这类细菌是常见的引发人体腹泻、肺炎、伤口感染等病症的病原微生物。
北京协和医院检验科大夫表示,呼吸科、皮肤科、消化科、骨科、妇科等诸多科室有超过40%的疾病与细菌有关,而医院的重症监护病房(ICU)由于其接收病人的特殊性,也成为医院感染的高危科室之一,而快速准确检测细菌可以正确指导医生用药,避免使用无效抗生素引发的药物滥用问题,同时也能提高救治因细菌感染导至病情加重的患者的效率。据协和医院检验科专家介绍说,北京协和医院本次使用这款国产质谱仪评估了该院1999年-2000年、2014年-2016年间所保存的1025株革兰氏阴性菌,包括大肠埃希菌、流感嗜血杆菌及铜绿假单胞菌等,同时利用国外先进的布鲁克质谱系统进行对比。检测结果显示,这款国产质谱仪(Clin-ToF)鉴定的准确率达98.05%,在革兰氏阴性菌方面的鉴定能力和效率方面,与国际领先技术相当。
根据该评估实验所撰写的论文已于近日发表在《中华检验医学杂志》上。
据介绍,革兰氏阴性菌是多种细菌的统称,包括痢疾杆菌、肺炎杆菌、流感(嗜血)杆菌、百日咳杆菌等致病细菌,而运用质谱仪来检验细菌是检验医学领域的新技术。这种检测设备能够准确、快速地鉴定患者体内致病细菌的耐药性。通过对质谱分析,可以判断对细菌的蛋白质进行鉴定,准确判断出其对哪一种抗生素具有耐药性,从而帮助医生拟定更精确的治疗方案,避免不能准确判断时,可能要尝试多种抗生素才能找到有效药物的情况出现,从而实现个体化精准治疗,并遏制治疗过程中的抗生素滥用。
然而,此前很多临床微生物实验室都面临着标本检测周期过长的问题,运用质谱检测技术则可缩短至少1天的鉴定时间,而有研究证实,在重症监护室(ICU)临床治疗中,抗生素如果晚一小时准确治疗,病人存活率下降8%。因此,这种技术也被认为是临床微生物实验室的革命,而我国此前在该领域尚无自主产品。此次检测可以说是国产医学检验质谱仪的一大突破,北京协和医院已将该仪器应用于临床检测。
实际上,除了在医疗领域之外,微生物检测在食品安全、生物安全等领域都有着极为重要的意义。而毅新博创公司在国家重大科学仪器设备开发专项项目的支持下,与军事医学科学院等机构合作,已经建立了包含2200种微生物蛋白指纹图谱的数据库,可以实现以蛋白指纹图谱对微生物进行管理。据介绍,蛋白指纹图谱是每种微生物的标志物,类似于人类的指纹一样,建立这个数据库就如同给细菌一个身份证,据此可以准确辨别它们,从而为防止微生物危害人体健康筑好屏障。(生物谷Bioon.com)